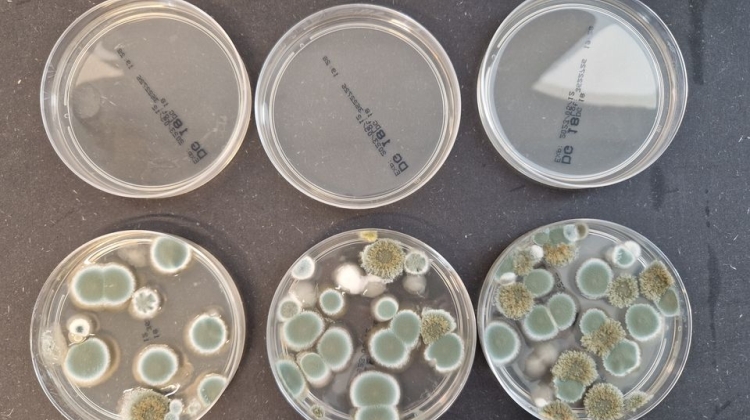

Skimmel i hospitalsbygninger er et voksende problem, der truer både patientsikkerheden og bygningsdriften. Fugt, ventilationssystemer og ældre konstruktioner skaber ideelle forhold for vækst af skimmelsvamp, som kan have alvorlige konsekvenser for patienter med svækket immunforsvar.
Nu bliver den internationalt anerkendte Far-UVC 222 nm teknologi tilgængelig i Danmark gennem den danske virksomhed UV Medico, som bringer løsningen ind på hospitaler og i andre kliniske miljøer.
– Skimmel i hospitalsmiljøer er ikke kun et bygningsproblem – det er et sundhedsproblem. Far-UVC giver hospitaler en ny mulighed for at forebygge vækst og sikre et sundt indeklima uden at forstyrre driften, siger Peter Johansen, CEO hos UV Medico.
Sikker og kontinuerlig desinfektion med lys
Far-UVC-lys ved 222 nanometer dræber mikroorganismer som skimmelsporer, bakterier og virus – men trænger ikke gennem hud eller øjne. Det gør teknologien sikker til brug i rum med mennesker, og dermed ideel til hospitaler, operationsgange, patientområder og teknikrum.
Løsningen forebygge skimmelvækst i fugtige og utilgængelige områder, reducere luftbårne infektioner kontinuerligt og minimere brugen af kemiske rengøringsmidler og energi til udtørring
Far-UVC kan integreres i eksisterende loftsbelysning eller installeres som selvstændige enheder, der arbejder automatisk og lydløst.
Far-UVC er allerede udbredt på hospitaler i mange andre lande. Således har UV Medico i dag mere end 13.000 installationer globalt, hvilket understreger teknologiens pålidelighed, effektivitet og modenhed.
Den danske version af teknologien er udviklet i samarbejde med Aarhus Universitet og bygger på international forskning, der dokumenterer både sikkerhed og effekt.
– Vi er stolte af at bringe denne teknologi til Danmark og gøre den tilgængelig for danske hospitaler og sundhedsbygninger, siger Peter Johansen.
Kilde: UV Medico

